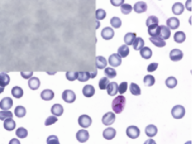
Refer to caption

SHAP-XRT: The Shapley Value Meets
Conditional Independence Testing
Abstract
The complex nature of artificial neural networks raises concerns on their reliability, trustworthiness, and fairness in real-world scenarios. The Shapley value—a solution concept from game theory—is one of the most popular explanation methods for machine learning models. More traditionally, from a statistical perspective, feature importance is defined in terms of conditional independence. So far, these two approaches to interpretability and feature importance have been considered separate and distinct. In this work, we show that Shapley-based explanation methods and conditional independence testing are closely related. We introduce the SHAPley EXplanation Randomization Test (SHAP-XRT), a testing procedure inspired by the Conditional Randomization Test (CRT) for a specific notion of local (i.e., on a sample) conditional independence. With it, we prove that for binary classification problems, the marginal contributions in the Shapley value provide lower and upper bounds to the expected -values of their respective tests. Furthermore, we show that the Shapley value itself provides an upper bound to the expected -value of a global (i.e., overall) null hypothesis. As a result, we further our understanding of Shapley-based explanation methods from a novel perspective and characterize the conditions under which one can make statistically valid claims about feature importance via the Shapley value.
1 Introduction
Deep learning models have shown remarkable success in solving a wide range of problems, from computer vision and natural language processing, to reinforcement learning and scientific research [45]. These exciting results have come hand-in-hand with an increase in the complexity of these models, mostly based on neural networks. While these systems consistently set the state-of-the-art in many tasks, our understanding of their specific mechanisms remains intuitive at best. In fact, as neural networks keep getting deeper and wider, they also become opaque (or unintelligible) to both developers and users. This lack of transparency is usually referred to as the black-box problem: the predictions of a deep learning model are not readily interpretable, entailing theoretical, societal, and regulatory issues [89, 80, 73]. For example, certain regulations may require companies and organizations who rely on autonomous systems to provide explanations of their decisions (e.g., what lead a model to reject a loan application) [9, 40, 30]. Finally, it is still unclear whether a loss of interpretability is unavoidable to increase performance [66].
These concerns on the reliability and trustworthiness of machine learning have motivated recent efforts on explaining predictions. A distinction exists between inherently interpretable models and explanation methods. The former are designed to provide predictions that can be understood by their users. For example, rule-based systems and decision trees are considered inherently interpretable because it is possible to trace a prediction through the specific rules or splits learned by the model. On the other hand, when models are not explicitly designed in an interpretable fashion (e.g., deep neural networks), we usually rely on a-posteriori explanation methods to find the most important features towards a prediction. These methods assign an importance score to every feature (or groups thereof) in the input, and the resulting scores can be presented to a user as an explanation of the prediction. Explanation methods have been widely adopted given their easy implementation and their ability to explain any model, i.e. they can be model-agnostic. Since the introduction of CAM [90], DeepLift [74], and LIME [64], the explainability literature has witnessed remarkable growth, and various approaches have been proposed to identify important features [67, 51, 12, 16, 42, 39, 43, 77, 56] with varying degrees of success [2, 71].
The SHAP framework [51] unifies several existing methods while providing explanations that satisfy some desirable theoretical properties. More precisely, it brings the Shapley value [72]—a solution concept from game theory [60]—to bear in the interpretation of machine learning predictors. In cooperative game theory, a solution concept is a formal rule that describes the strategy that each player will use when participating in a game. For Transfer Utility (TU) games, the Shapley value is the only solution concept that satisfies the properties of additivity, nullity, symmetry, and linearity, and it can be derived axiomatically.111In a TU game, players can exchange their utility without incurring in any cost. In the context of explainability, the SHAP framework considers a TU game represented by the predictive model, where every feature in the input is a player in the game, and it computes their Shapley values as a measure of feature importance.222Herein, we will implicitly refer to the Shapley value of a feature according to the definition of SHAP attribution in Lundberg and Lee [51]. We remark that the axiomatic characterization of the Shapley value implies that it is the only explanation method that satisfies these theoretical properties. The most important limitation of the Shapley value is its exponential computational cost in the number of players (i.e., the input dimension), which quickly becomes intractable for several applications of interest. Thus, most Shapley-based methods rely on various strategies to approximate them [11], some with finite-sample, non-asymptotic, and efficiency guarantees [12, 52, 77]. An alternative approach is to relax some of the axioms. This yields several other explanation methods based on a feature’s marginal contribution, such as semivalues [21] and random order values [25].
While theoretically appealing, and often useful in practice, this Shapley-based approach to interpretability remains questionable:
| What does it mean for a feature to receive a large Shapley value? |
Previous works have explored the connection between feature selection and the Shapley value [14, 26, 65] as well as some statistical implications of large (or small) Shapley values [59, 35, 53, 82, 83]. However, a general and precise connection between the Shapley value and statistical importance has been missing. In particular, it is unclear how to provide false positive rate control (i.e., to control the Type I error) when feature selection is performed on the basis of Shapley values. This is a fundamental issue as explanation methods are increasingly used in high-stakes scenarios to inform decision making, especially in medicine [91, 18, 49]. For example, consider a clinical setting where a predictor is used to support diagnosis and treatment. Given each feature’s Shapley value, which ones should we deem important? If a patient’s age, blood pressure, weight, and height receive Shapley values of 0.30, 0.15, 0.35, and 0.20, respectively, which should we report? We could decide to report the most important feature (i.e., weight). This choice will likely underreport findings and potentially mislead the clinician. Symmetrically, reporting all features with a positive Shapley value would be uninformative with respect to the decision process of the model. This example shows the lack of a rigorous way to perform statistically-valid feature selection by means of the Shapley value, and how overlooking this question could lead to potentially harmful consequences in real-world scenarios.
In this paper, we show how relating the Shapley value to statistical notions of conditional independence provides a principled way to select important features. Indeed, the statistics literature has a rich history of studying variable selection problems [5, 37, 29], for example, via conditional independence testing and controlled variable selection [8]. That is, a feature is unimportant if it is independent of a response once conditioned on the remaining features. In other words, knowing the value of an unimportant feature does not provide any more information about the response when the rest of the data is known. The Conditional Randomization Test (CRT) [8] is a conditional independence test that does not make any assumptions on the conditional distribution of the response given the features, while assuming that the conditional distribution of the features is known instead. This setting is particularly useful in applications where unlabeled data may be abundant compared to labeled data (e.g., genomics research, as shown in [8, 69, 68], or imaging data [58]). While the original CRT procedure is computationally intractable for large models, fast and efficient alternatives have been recently proposed, such as the the Holdout Randomization Test (HRT) by [76] and the Distilled Conditional Randomization Test (DCRT) by [47].
We remark that in this paper we consider feature importance with respect to the response of a fixed predictive model on an individual sample. This differs from the traditional statistical setting in which one analyzes features with respect to an observed response at the population level. Nonetheless, this notion of interpretability is important in many scenarios. For example, one may wish to understand the important features for a model that computes credit scores [19, 6], or one may need to verify that the important features for the prediction of an existing, complex model agree with prior-knowledge [7, 39, 23].
1.1 Related work
Previous works have explored granting the Shapley value with some statistical notion of importance. For example, [59] and [82, 83] study the Shapley value for correlated variables in the context of ANalysis Of VAriance (ANOVA) [35] and Leave Out COvariates (LOCO) [46] procedures, respectively. Importantly, [82] precisely raise the issue of the lack of statistical meaning for large (or small) Shapley values when features are correlated. Information-theoretic interpretations of the Shapley value have also been proposed. SAGE [15] translates the Shapley value from local (i.e., on a sample) to global (i.e., over a population) feature importance, and shows connections to mutual information. Most recently, [86] propose a modified Shapley value with precise information-theoretical properties to study the independence between the true response and the features. In the context of data attribution methods, [28] define the Distributional Shapley value to include information about the underlying data distribution into the original Shapley value. Finally, and most closely to this work, [53] try and deploy ideas of conditional independence to the Shapley value for causal inference on data generated by a Bayesian network. Our work differs from these, as we now summarize.
1.2 Contributions
In this paper, we will show that for machine learning models, computing the Shapley value of a given input feature amounts to performing a series of conditional independence tests for specific feature importance definitions. This is different from [86] in that we do not assume the predictor to be the true conditional distribution of the response given the features. As we will shortly demonstrate, the computed game-theoretic quantities provide upper and lower bounds to the -values of their respective tests. This novel connection provides several popular explanation techniques with a well-defined notion of statistical importance. We demonstrate our results with simulated as well as real imaging data. We stress that we do not wish to introduce a novel explanation method for model predictions. Our aim is instead to expand our fundamental understanding of the Shapley value when applied to machine learning models, particularly as its use for the interpretation of predictive models continues to grow [55, 91, 48]. These novel insights should inform the design of explanation methods to guarantee the responsible use of machine learning models.
2 Background
Before presenting the contribution of this work, we briefly introduce the necessary notation and general definitions. Herein, we will denote random variables and random vectors with capital letters (e.g., ), their realizations with lowercase letters (e.g., ) and random matrices with bold capital letters (e.g., ). Let be some input and response domains, respectively, such that is a random sample from an unknown distribution over . We set ourselves within the classical binary classification setting. Given , the task is to estimate the binary response on a sample by means of a predictor that approximates the conditional expectation of the response on an input, i.e. . We will not concern ourselves with this learning problem. Instead, we assume we are given a fixed predictor which we wish to analyze. More precisely, for an input , we want to understand the importance of the features in , i.e. , with respect to the value of . This question will be formalized by means of the Shapley value, which we now define.
2.1 The Shapley value
In game theory (see, e.g., [63]), the tuple represents an -person cooperative game with players and characteristic function , where is the power set of . For any subset of players , the characteristic function outputs a nonnegative score that represents the utility accumulated by the players in . Furthermore, one typically assumes . A Transfer Utility (TU) game is one where players can exchange their utility without incurring any cost. Given a TU game , a solution concept is a formal rule that assigns to every player in the game a reward that is commensurate with their contribution. In particular, there exists a unique solution concept that satisfies the axioms of additivity, nullity, symmetry, and linearity [72] (see Appendix B for details on the axioms). This solution concept is the set of Shapley values, , which are defined as follows.
Definition 1 (Shapley value).
Given an -person TU game , the Shapley value of player is
| (1) |
where . That is, is the average marginalized contribution of the player over all subsets (i.e., coalitions) of players.
2.2 Explaining model predictions with the Shapley value
Definition 1 shows how to compute the Shapley value for players in a TU game, and it is not immediately clear how this would apply to machine learning models. To this end, let be the prediction of a learned model on a new sample . For any set of features , denote the entries of in the subset (analogously, for , the complement of ). We will refer to
| (2) |
as the random vector that is equal to in the features in and that takes a random reference value in its complement . Following [51], we let be sampled from its conditional distribution given , i.e. .333Herein, we do not touch upon the discussion on observational vs. interventional Shapley values, and we refer the interested reader to [75, 10, 54, 38]. Note that, in this way, is independent of the response by construction. For the sake of simplicity, we write . Then, for a predictor and every subset , is a random variable whose source of randomness is the random reference value.444When , is simply the prediction , which is not random. This way, with abuse of notation, one can define the TU game , where every feature in the sample is a player in the game. Therefore, analogous to Definition 1, the Shapley value of feature is
| (3) |
We note that can be negative, i.e. feature has an overall negative contribution to the prediction of the model. This differs from the game-theoretical setting where feature attributions are usually considered nonnegative. In the context of explainability, we look for a subset (e.g., the smallest subset) such that are the observed features that contributed the most towards .
We remark two main differences between the original definition of the Shapley value from game theory (Eq. 1) and its translation to machine learning models (Eq. 3) in common settings: the characteristic function can predict on sets of players, whereas the predictive model typically has a fixed input domain (e.g., for a convolutional neural network);555As noted in [36, 17, 78]: Deep Sets [88] and Transformers [81] architectures do not suffer from this limitation. and the characteristic function is usually not data-dependent, while in this machine learning setting the model was trained on samples from a specific distribution . As a result, given a subset of features , one cannot simply predict on the partial input vector because is not defined. Instead, the missing features in the complement of must be masked with a reference value that does not contain any information about the response in order to simulate their absence. Furthermore, this reference value must come from the same data distribution the model was trained on, hence the need to sample from the conditional distribution [24, 1]. Both the need to approximate the conditional distribution as well as the exponential number of summands in Eq. 3 make the exact computation of Shapley values intractable in general.
2.3 The Conditional Randomization Test (CRT)
Before introducing our novel conditional independence testing procedure, we provide a brief summary of feature importance from the perspective of conditional independence. Given random variables , and we say that is independent of given (succinctly, ) if , where indicates equality in distribution. Put into words, knowing does not provide any more information about in the presence of . Recall that for each is a random variable that corresponds to the feature in , and is its complement. Then, the CRT procedure by [8] implements a conditional independence test for the null hypothesis
| (4) |
which can be directly rewritten as666Note that Eq. 5 is equivalent to .
| (5) |
Let be null duplicates of . are called nulls because, by construction, they are conditionally independent of the response given . Under , for any choice of test statistic , the random variables are i.i.d., hence exchangeable [3]. Then, —the -value returned by the CRT—is valid: under , [see 8, Lemma F.1]. For completeness, Algorithm C.1 summarizes the CRT procedure.
3 Hypothesis testing via the Shapley value
Given the above background, we will now show that the Shapley value for machine learning explainability (Eq. 3) is tightly connected with conditional independence testing. Formally, we present the SHAPley EXplanation Randomization Test (SHAP-XRT): a novel modification of the CRT that—differently from the original motivation in Candes et al. [8]—evaluates conditional independence of the response of a deterministic model on an individual sample . That is, SHAP-XRT, akin to the CRT, provides a permutation-based -value to test for the conditional independence of two distributions without making any assumptions on the conditional distribution of the prediction of the model, while requiring access to the conditional distribution of the data. Differently from the CRT, the distributions considered by SHAP-XRT are built on top of a single observation instead of over a population, and the response is a deterministic function of the input rather than a random variable. As we will present shortly, there is a fundamental difference between the Shapley value and SHAP-XRT; the former computes the average marginal contribution of a feature by differences of conditional expectations, whereas the latter provides a -value for a test of equality in distribution.
3.1 The Shapley Explanation Randomization Test (SHAP-XRT)
Going back to our motivating example of an automated system in a clinical setting, we would like to deploy ideas of conditional independence testing to report the most important features for the model’s prediction on a patient. For example, we might be interested in knowing whether the response of the model on a specific patient is independent of age when their blood pressure and weight are collected. This way, we could provide precise statistical guarantees on the generated explanations, such as Type I error control. More precisely, this is equivalent to testing for the independence of the response of a model on a feature when the features in are observed (e.g., and ). We now formalize this question by means of our novel SHAP-XRT null hypothesis.
Definition 2 (SHAPley EXplanation Randomization Test).
Let and be a fixed predictor for a binary response on an input such that . Given a new sample , a feature , and a subset of features , denote the corresponding random vector where is sampled from its conditional distribution given . Then, the SHAP-XRT null hypothesis is
| (6) |
Recall that and are random vectors equal to in the features in and , respectively, and that take unimportant random reference values in their complements (Eq. 2). Then, the SHAP-XRT null hypothesis is equivalent to
| (7) |
which precisely asks whether the distribution of the response of the model changes when feature is added to the subset .
How should one test for this null hypothesis? Denote and the random matrices containing duplicates of and , respectively, such that and are the predictions of the model. Algorithm 1 implements the SHAP-XRT testing procedure and it computes the respective -value, , for any choice of test statistic on the response of the model, e.g. the mean. We now formally state the validity of this test.
Theorem 1 (Validity of ).
Under the null hypothesis , —the -value returned by the SHAP-XRT procedure—is valid for any choice of test statistic , i.e. .
We defer the brief proof to Section A.1.
We remark that the -value returned by the SHAP-XRT procedure—akin to other conditional independence tests—is one-sided. Rejecting implies that in the presence of the features in , the observed value of feature is important in the sense that is often larger (i.e., closer to 1), or stochastically greater, than . If one desires to reject for features whose is often smaller than , it suffices to use in lieu of . Note that the SHAP-XRT procedure encompasses multi-class classification settings where predicts one of classes and . Furthermore, can be generalized to any predictor for arbitrary domains, but we consider binary classification in this work.
We stress that in contrast with the CRT null hypothesis (Eq. 4), is defined locally on a specific input rather than over a population. Differently from the Interpretability Randomization Test (IRT) by [7] asks for the conditional independence of the response with respect to a single feature rather than a collection of subsets of features, and it allows to condition on arbitrary subsets of features instead of restricting to , i.e. all features but .
Finally, let us make a remark about the involved distributions. Recall that the SHAP-XRT procedure is defined locally on a sample . Intuitively, under the null , the distribution of the response of the model is independent of (the observed value of the feature in ) conditionally on . Since is a deterministic function of its input, it is natural to ask when the random variable has a degenerate distribution. Suppose that for each is not degenerate (e.g., it is not constant), otherwise is trivially degenerate. For (i.e., all features but the one), because by definition of the complement set is empty, i.e. no reference value is sampled. It follows that for this choice of , is point mass at , and SHAP-XRT retrieves the IRT procedure [7].
3.2 Connecting the Shapley value and the SHAP-XRT conditional independence test
We now draw a precise connection between the SHAP-XRT testing procedure and the Shapley value for machine learning explainability. This novel relation furthers our fundamental understanding of Shapley-based explanation methods, and, importantly, it clarifies under which conditions one can (and cannot) make statistically valid claims about feature importance. We stress that—as we will discuss—this conditional independence interpretation is not intended to overcome the well-known computational limitations of the Shapley value nor to replace existing methods. Rather, it offers a previously overlooked perspective, and it suggests new strategies to develop more powerful, statistically well-grounded alternatives. To begin with, let in the SHAP-XRT procedure be the identity and set (we will discuss the effect of on our results later). Then, for a sample , a feature , and a subset , the SHAP-XRT test and null statistics become and , respectively. Denote
| (8) |
the random marginal contribution of feature to the subset such that
| (9) |
are the expected -value of the SHAP-XRT procedure and the expected marginal contribution, respectively. Note the expectations are over both and . This is to take into account the randomness in the draw of test statistic . Then, it is easy to see that the Shapley value of feature can be rewritten as
| (10) |
We now show that each summand can be used to construct both upper and lower bounds to .
Theorem 2.
Let , and be a fixed predictor for a binary response on an input such that . Given a sample , a feature , and a subset , define such that and . Then,
| (11) |
and furthermore, if
| (12) |
where is the number of draws of null statistic in the SHAP-XRT procedure.
We defer the proof of this result to Section A.2. We note that the theorem above is presented in expectation, and an analogous finite-sample result can be derived by means of concentration inequalities by estimating with an empirical mean (as long as it is computed over samples independent of ). We now discuss the meaning of Theorem 2 and its behavior as a function of and in the SHAP-XRT procedure, i.e. the number of draws of null statistic and the number of random reference values sampled at each iteration, respectively.
Behavior of Eqs. 11 and 12 as a function of .
As , i.e. as the number of draws of null statistic in the SHAP-XRT procedure goes to infinity, , and Eqs. 11 and 12 become
| (13) |
respectively. Furthermore, we remark that the coefficient in the bounds above is a mild requirement in practical scenarios. In particular, in order to expect to reject at level for , it suffices for to grow as (e.g., ).
Behavior of as a function of .
Recall that is the number of samples of reference values over which the test and null statistics are computed in the SHAP-XRT procedure. So far, we presented our results for and being the identity. These choices were instrumental for showcasing the connection between the SHAP-XRT test and the Shapley value. Here, we discuss the behavior of the SHAP-XRT -value as increases. First note that if , the test statistic cannot simply be the identity because is a function that maps . The SHAP-XRT procedure is valid for any choice of test statistic, , and so for , choices of mean, median, quantile, max, etc, are all valid. For example, let be the mean and in the limit , and . Then, .
Implications of Theorem 2
The result above provides a novel understanding of the Shapley value from a conditional independence testing perspective. In particular, it shows that each summand (i.e., the expected marginal contribution of feature to subset ) in the Shapley value of feature provides a lower and an upper bound to , the expected -value of its corresponding SHAP-XRT test (i.e., the test which asks whether the distribution of the response of the model is conditionally independent of when the features in are present). Until now, it was unclear whether the marginal contributions carried any statistical meaning. Theorem 2 precisely characterizes under which conditions one can (and cannot) use them to make statistically valid claims about feature importance. In particular, given a critical level in the SHAP-XRT test, we can identify three separate conditions:
-
1.
large positive contributions (i.e., ) can provide sufficient evidence against the null hypothesis , and so one can expect to reject it.
-
2.
large negative contributions (i.e., ) cannot provide sufficient evidence against the null hypothesis , and so one should not expect to be able to reject it.
-
3.
small contributions (i.e., ) are noninformative, and so one cannot expect to make any statistically valid claims.
Fig. 1 illustrates the bounds (when ) and the three regimes described above.
3.3 The Shapley value as a global hypothesis test
The results presented so far study the statistical meaning of each summand (i.e., contribution) in the Shapley value. However, the overall Shapley value—and not just its individual summands—is used in practice to explain model predictions. Since every summand is linked to the -value of a specific local hypothesis test, a naive approach would be to compare all -values to level , where rejecting at least one hypothesis implies feature is important with respect to some subset . However, this approach is known to inflate the Type I error, and corrections are required (i.e., Bonferroni correction [70]). Instead, we ask whether the Shapley value is inherently linked to a global hypothesis test.777Here, the term global is used according to its meaning in the statistical theory literature, and not in the machine learning explainability literature. If so, what is the null hypothesis of this test? and what notion of importance does it convey? We now move onto answering these questions, for which we first introduce the definition of a global hypothesis test.

Given null hypotheses with their respective -values , the global null hypothesis is defined as and it is true if and only if every individual null hypothesis is true [33]. Several classical procedures exist for global hypothesis testing, both based on the ordering of the -values of the individual tests [34] and on ways of combining them [79, 62, 22]. More powerful alternatives have been recently proposed to overcome some of the limitations of these long-established methods, and, importantly, to make no assumptions on the dependency structure of the individual -values [32, 27, 87, 84, 49].
With the above background, we now show how to aggregate all SHAP-XRT tests for feature into a global SHAP-XRT null hypothesis test, provide a valid -value for it, and finally highlight its relation to the Shapley value of feature . Recall that there exists a SHAP-XRT test with null hypothesis for each . Using all these tests, we can define the global null hypothesis
| (14) |
which is false as soon as one of the hypotheses is false. Put into words, rejecting implies that feature is important (i.e., it has an effect on the distribution of the response of the model) with respect to at least one subset . This way, tests for a global notion of importance of feature over all possible conditioning subsets. We remark that this is possible precisely because SHAP-XRT—differently from other conditional independence tests—allows to condition on arbitrary subsets of features. We now provide a valid -value for this global test.
Lemma 1.
In the setting of Definition 2, and under the global null hypothesis (Eq. 14) the random variable
| (15) |
is a valid -value, i.e. .
This statement follows directly from [84, Proposition 9] and its proof is included in Section A.3. We remark that the choice of weights is not unique as long as they belong to the simplex. Here, we use the same weights as the Shapley value’s (i.e., uniform distribution over all possible subsets), as this will allow us to show that overall Shapley value of feature indeed provides an upper bound to the expected -value for the global SHAP-XRT test. Alternative weighting functions—which give rise to semivalues [21, 85] and random order values [25]—are subject of current research [44] and we consider the study of their statistical meaning as future work.
Corollary 1.
Denote the expected -value for the global null . Then,
| (16) |
where is the Shapley value of feature .
The proof is included in Section A.4. This result shows that the Shapley value itself, and not only its summands, provides an answer to a statistical test. A straightforward implication of this result is that, given a desired significance level , one can expect to reject when . In simple terms, a large positive Shapley value, , implies that there exists at least one for which its expected p-value, is small and is expected to be rejected. This result grants the Shapley value statistical meaning by demonstrating that it is linked to a global hypothesis test.
The natural questions that remain are then: when which tests, amongst , are being rejected? and similarly, do large negative Shapley values, , carry any statistical meaning? We answer these questions with the following corollary in a similar fashion to Theorem 2.
Corollary 2.
For a feature , if , then
| (17) |
where . Furthermore, if with , then
| (18) |


The proof is included in Section A.5, and we now provide a few remarks. Firstly, Corollary 2 grants large positive (i.e, ) and large negative (i.e., ) Shapley values with statistical meaning. Recall from Corollary 1 that one can expect to reject the global null for large positive values of . This means that at least one of the SHAP-XRT null hypotheses of feature is expected to be false. In other words, there exists at least one subset such that affects the distribution of the response of the model when the features in are present. Corollary 2 makes this statement more precise. In fact, it shows that all SHAP-XRT tests needs to have small -values, and one should expect to reject all tests. Symmetrically, it shows that for large negative Shapley values, one cannot expect to reject any SHAP-XRT null hypothesis for feature . That is, feature does not contribute to the distribution of the response of the model given any subset .
Secondly, Corollary 2 offers a statistical interpretation of the exponential cost of the Shapley value. Note that for the upper bound in Eq. 17 not to be vacuous (i.e., less than 1) and for the lower bound in Eq. 18 to hold (i.e., all contributions be negative), must be smaller than (i.e., for Eq. 17, and for Eq. 18 by construction). For features, the weights in the Shapley value assign a uniform distribution over all possible subsets . It follows that is the inverse of the central binomial coefficient, i.e. by Stirling’s approximation. Then, needs to decay exponentially fast with for the bounds to be informative. This is a well-known limitation of the Shapley value in practical high-dimensional settings. We remark that studying under which settings the computational cost of the Shapley value can be reduced is subject of ongoing research that is orthogonal to the contribution of this paper [13, 52, 77]. Rather, Corollary 2 shows the statistical implications of the exponential number of subsets one needs to account for when computing the Shapley value of feature .
Finally, Corollaries 1 and 2 open the door to variations of the Shapley value inspired by more sophisticated and powerful ways of combining -values other than averaging, which may provide more effective in practice while guaranteeing false positive rate control. We consider these potential extensions as part of future work.
4 Experiments
We now present three experiments, of increasing complexity, that showcase how the SHAP-XRT procedure can be used in practice to explain machine learning predictions, contextualizing the Shapley value from a statistical viewpoint. All code to reproduce experiments will be made publicly available.


Known response function
We first study a case where both the distribution of the data and the ground-truth function are known. Let such that and denote the concatenation of vectors . We define the ground-truth function where is the sigmoid function888. and . For , and if and otherwise. We set and let with the exception that . We concern ourselves with the null hypothesis with and . That is, we are aiming to detect when (i.e., feature ) increases the value of relative to in the presence of (i.e., the features in ). Using the SHAP-XRT procedure with = 100, we calculate and for 1000 samples. In Fig. 2(a), for all samples with , we plot as a function of and display the upper bound . To demonstrate the validity of the lower bound, we keep the experiment the same except that now . In Fig. 2(b), for all samples with , we plot as a function of and display the lower bound . Fig. F.3 shows the gap between performing conditional independence testing by means of marginal contributions () or SHAP-XRT -values () as a function of the significance level by estimating .
Synthetic image data
We now present a case where the distribution of the data is known, but we can only estimate the response through some learned model. Let be images composed of an grid of non-overlapping patches of pixels, such that is the patch in the -row and -column. We consider a synthetic dataset of images where the response is positive if the input image contains at least one instance of a target signal . Denote images in as vectors in , and let be random noise. Define an important distribution for some target signal , and its unimportant complement , such that and are independent Bernoulli random variables with parameter . Then, . In particular, we let and be a cross (an example is presented in Fig. 1(a)). Furthermore, we set such that . Fig. F.1 shows some example images and their respective labels for different noise levels . We train a Convolutional Neural Network (CNN) and a Fully Connected Network (FCN) to predict the response (see Section D.1 for further details). Recalling that the power of a test is defined as , we estimate the power of performing conditional independence testing via Shapley coefficients at a chosen level by evaluating on a test dataset of 320 samples. We remark that is false for all patches such that . Fig. 3 shows an estimate of the power of for both models as a function of number of samples shown during training (Fig. 3(a)), and noise in the test data (Fig. 3(b)) over 5 independent training realizations.
Real image data
Finally, we revisit an experiment from [77] on the BBBC041 dataset [50], which comprises 1425 images of healthy and infected human blood smears of size pixels. The objective of this experiment is to showcase how Theorem 2 translates to a real-world scenario where the same object of interest receives two different Shapley values, and how this affects the -values of the individual SHAP-XRT null hypotheses. Here, the task is to label positively images that contain at least one trophozoite—an infectious type of cell. We apply transfer-learning to a ResNet18 [31] pretrained on ImageNet [20] (see Section D.2 for further details). After training, our model achieves a validation accuracy greater than 99%. Computing the exact Shapley value for each pixel is intractable, hence we take an approach similar to that of h-Shap [77] and define features as quadrants in order to compute the -value of each SHAP-XRT null hypothesis. Since there are 4 quadrants, each Shapley value () comprises only 8 marginal contributions () that can be computed exactly without any need for approximation. We extend the original implementation of h-Shap to return the SHAP-XRT tests that reject (or fail to reject) their respective nulls, thus assigning a collection of -values to every quadrant. We note that in this experiment, we use the unconditional expectation over the training set to mask features—as it is commonly done in popular Shapley-based explanation methods. Fig. F.2 shows the reference value used for masking and some example masked inputs. Fig. 4 presents the two examples. The first, Fig. 4(a), depicts a case where there exists only 1 cell in the upper right quadrant, i.e. . Thus, this quadrant receives a Shapley value . Naturally, all -values are approximately zero (as also guaranteed by Corollary 2). This implies that the quadrant is statistically important in the sense that all SHAP-XRT null hypotheses are rejected. On the other hand, in Fig. 4(b), there are two quadrants that contain sick cells, i.e. , and by symmetry. Based on our theoretical results, and can be decomposed in the sum of 8 terms that bound the -values of their respective SHAP-XRT tests. As can be seen, is indeed statistically important in that half of the null hypotheses are rejected (i.e., all tests such that ). However, the bound in Corollary 1 shows that a Shapley value of is not large enough to reject the global null even if it is clearly false. These results highlight the suboptimality of the Shapley value from a statistical testing perspective, which motivates future work to develop more powerful alternatives. We expand on this experiment in Appendix E.


5 Conclusion
The Shapley value and conditional hypothesis testing appear as two unrelated approaches to local (i.e., sample specific) interpretability of machine learning models. In this work, we have shown that the two are tightly connected in that the former involves the computation of specific conditional hypothesis tests, and that every summand in the Shapley value can be used to bound the -values of such tests. For the first time, this perspective grants the Shapley value with a precise statistical meaning. We presented numerical experiments on synthetic and real data of increasing complexity to depict our theoretical results in practice. We hope that this work will enable the further and precise understanding of the meaning of (very popular) game theoretic quantities in the context of statistical learning. Restricting the Shapley value to an a-priori subset of null hypotheses may prove successful in devising useful algorithms in certain scenarios, and alternative ways other than the weighted arithmetic mean—which is employed by the Shapley value—may yield powerful procedures to combine SHAP-XRT’s -values to test for global null hypotheses.
Acknowledgments
The authors thank the anonymous reviewers who helped improve the clarity and presentation of this manuscript. This research was supported by the NSF CAREER Award CCF 2239787. Y. R. was supported by the Israel Science Foundation (grant No. 729/21). Y. R. also thanks the Career Advancement Fellowship, Technion, for providing research support.
References
- Aas et al. [2021] Kjersti Aas, Martin Jullum, and Anders Løland. Explaining individual predictions when features are dependent: More accurate approximations to shapley values. Artificial Intelligence, 298:103502, 2021.
- Adebayo et al. [2018] Julius Adebayo, Justin Gilmer, Michael Muelly, Ian Goodfellow, Moritz Hardt, and Been Kim. Sanity checks for saliency maps. Advances in neural information processing systems, 31, 2018.
- Berrett et al. [2020] Thomas B Berrett, Yi Wang, Rina Foygel Barber, and Richard J Samworth. The conditional permutation test for independence while controlling for confounders. Journal of the Royal Statistical Society: Series B (Statistical Methodology), 82(1):175–197, 2020.
- Bhatia and Davis [2000] Rajendra Bhatia and Chandler Davis. A better bound on the variance. The american mathematical monthly, 107(4):353–357, 2000.
- Blum and Langley [1997] Avrim L Blum and Pat Langley. Selection of relevant features and examples in machine learning. Artificial intelligence, 97(1-2):245–271, 1997.
- Bücker et al. [2022] Michael Bücker, Gero Szepannek, Alicja Gosiewska, and Przemyslaw Biecek. Transparency, auditability, and explainability of machine learning models in credit scoring. Journal of the Operational Research Society, 73(1):70–90, 2022.
- Burns et al. [2020] Collin Burns, Jesse Thomason, and Wesley Tansey. Interpreting black box models via hypothesis testing. In Proceedings of the 2020 ACM-IMS on Foundations of Data Science Conference, pages 47–57, 2020.
- Candes et al. [2018] Emmanuel Candes, Yingying Fan, Lucas Janson, and Jinchi Lv. Panning for gold: ‘model-x’ knockoffs for high dimensional controlled variable selection. Journal of the Royal Statistical Society: Series B (Statistical Methodology), 80(3):551–577, 2018.
- Casey et al. [2019] Bryan Casey, Ashkon Farhangi, and Roland Vogl. Rethinking explainable machines: The gdpr’s’ right to explanation’debate and the rise of algorithmic audits in enterprise. Berkeley Tech. LJ, 34:143, 2019.
- Chen et al. [2020] Hugh Chen, Joseph D Janizek, Scott Lundberg, and Su-In Lee. True to the model or true to the data? arXiv preprint arXiv:2006.16234, 2020.
- Chen et al. [2023] Hugh Chen, Ian C Covert, Scott M Lundberg, and Su-In Lee. Algorithms to estimate shapley value feature attributions. Nature Machine Intelligence, pages 1–12, 2023.
- Chen et al. [2018] Jianbo Chen, Le Song, Martin J Wainwright, and Michael I Jordan. L-shapley and c-shapley: Efficient model interpretation for structured data. arXiv preprint arXiv:1808.02610, 2018.
- Chen et al. [2019] Jianbo Chen, Le Song, Martin J. Wainwright, and Michael I. Jordan. L-shapley and c-shapley: Efficient model interpretation for structured data. In International Conference on Learning Representations, 2019.
- Cohen et al. [2007] Shay Cohen, Gideon Dror, and Eytan Ruppin. Feature selection via coalitional game theory. Neural Computation, 19(7):1939–1961, 2007.
- Covert et al. [2020] Ian Covert, Scott M Lundberg, and Su-In Lee. Understanding global feature contributions with additive importance measures. Advances in Neural Information Processing Systems, 33:17212–17223, 2020.
- Covert et al. [2021] Ian Covert, Scott Lundberg, and Su-In Lee. Explaining by removing: A unified framework for model explanation. Journal of Machine Learning Research, 22(209):1–90, 2021.
- Covert et al. [2022] Ian Covert, Chanwoo Kim, and Su-In Lee. Learning to estimate shapley values with vision transformers. arXiv preprint arXiv:2206.05282, 2022.
- de Almeida et al. [2022] Bernardo P de Almeida, Franziska Reiter, Michaela Pagani, and Alexander Stark. Deepstarr predicts enhancer activity from dna sequence and enables the de novo design of synthetic enhancers. Nature Genetics, 54(5):613–624, 2022.
- Demajo et al. [2020] Lara Marie Demajo, Vince Vella, and Alexiei Dingli. Explainable ai for interpretable credit scoring. arXiv preprint arXiv:2012.03749, 2020.
- Deng et al. [2009] Jia Deng, Wei Dong, Richard Socher, Li-Jia Li, Kai Li, and Li Fei-Fei. Imagenet: A large-scale hierarchical image database. In 2009 IEEE conference on computer vision and pattern recognition, pages 248–255. Ieee, 2009.
- Dubey et al. [1981] Pradeep Dubey, Abraham Neyman, and Robert James Weber. Value theory without efficiency. Mathematics of Operations Research, 6(1):122–128, 1981.
- Fisher [1948] R. A. Fisher. Questions and answers. The American Statistician, 2(5):30–31, 1948. ISSN 00031305. URL http://www.jstor.org/stable/2681650.
- Fong and Vedaldi [2017] Ruth C Fong and Andrea Vedaldi. Interpretable explanations of black boxes by meaningful perturbation. In Proceedings of the IEEE international conference on computer vision, pages 3429–3437, 2017.
- Frye et al. [2020a] Christopher Frye, Damien de Mijolla, Tom Begley, Laurence Cowton, Megan Stanley, and Ilya Feige. Shapley explainability on the data manifold. arXiv preprint arXiv:2006.01272, 2020a.
- Frye et al. [2020b] Christopher Frye, Colin Rowat, and Ilya Feige. Asymmetric shapley values: incorporating causal knowledge into model-agnostic explainability. Advances in Neural Information Processing Systems, 33:1229–1239, 2020b.
- Fryer et al. [2021] Daniel Fryer, Inga Strümke, and Hien Nguyen. Shapley values for feature selection: The good, the bad, and the axioms. IEEE Access, 9:144352–144360, 2021.
- Futschik et al. [2019] Andreas Futschik, Thomas Taus, and Sonja Zehetmayer. An omnibus test for the global null hypothesis. Statistical methods in medical research, 28(8):2292–2304, 2019.
- Ghorbani et al. [2020] Amirata Ghorbani, Michael Kim, and James Zou. A distributional framework for data valuation. In International Conference on Machine Learning, pages 3535–3544. PMLR, 2020.
- Guyon and Elisseeff [2003] Isabelle Guyon and André Elisseeff. An introduction to variable and feature selection. Journal of machine learning research, 3(Mar):1157–1182, 2003.
- Hacker et al. [2020] Philipp Hacker, Ralf Krestel, Stefan Grundmann, and Felix Naumann. Explainable ai under contract and tort law: legal incentives and technical challenges. Artificial Intelligence and Law, 28(4):415–439, 2020.
- He et al. [2016] Kaiming He, Xiangyu Zhang, Shaoqing Ren, and Jian Sun. Deep residual learning for image recognition. In Proceedings of the IEEE conference on computer vision and pattern recognition, pages 770–778, 2016.
- Heard and Rubin-Delanchy [2018] Nicholas A Heard and Patrick Rubin-Delanchy. Choosing between methods of combining-values. Biometrika, 105(1):239–246, 2018.
- Hommel [1983] Gerhard Hommel. Tests of the overall hypothesis for arbitrary dependence structures. Biometrical Journal, 25(5):423–430, 1983.
- Hommel et al. [2011] Gerhard Hommel, Frank Bretz, and Willi Maurer. Multiple hypotheses testing based on ordered p values—a historical survey with applications to medical research. Journal of biopharmaceutical statistics, 21(4):595–609, 2011.
- Hooker [2007] Giles Hooker. Generalized functional anova diagnostics for high-dimensional functions of dependent variables. Journal of Computational and Graphical Statistics, 16(3):709–732, 2007.
- Jain et al. [2022] Saachi Jain, Hadi Salman, Eric Wong, Pengchuan Zhang, Vibhav Vineet, Sai Vemprala, and Aleksander Madry. Missingness bias in model debugging. arXiv preprint arXiv:2204.08945, 2022.
- James et al. [2013] Gareth James, Daniela Witten, Trevor Hastie, and Robert Tibshirani. An introduction to statistical learning, volume 112. Springer, 2013.
- Janzing et al. [2020] Dominik Janzing, Lenon Minorics, and Patrick Blöbaum. Feature relevance quantification in explainable ai: A causal problem. In International Conference on artificial intelligence and statistics, pages 2907–2916. PMLR, 2020.
- Jiang et al. [2021] Peng-Tao Jiang, Chang-Bin Zhang, Qibin Hou, Ming-Ming Cheng, and Yunchao Wei. Layercam: Exploring hierarchical class activation maps for localization. IEEE Transactions on Image Processing, 30:5875–5888, 2021.
- Kaminski and Malgieri [2020] Margot E Kaminski and Gianclaudio Malgieri. Algorithmic impact assessments under the gdpr: producing multi-layered explanations. International Data Privacy Law, pages 19–28, 2020.
- Kingma and Ba [2014] Diederik P Kingma and Jimmy Ba. Adam: A method for stochastic optimization. arXiv preprint arXiv:1412.6980, 2014.
- Kolek et al. [2021] Stefan Kolek, Duc Anh Nguyen, Ron Levie, Joan Bruna, and Gitta Kutyniok. Cartoon explanations of image classifiers. arXiv preprint arXiv:2110.03485, 2021.
- Kolek et al. [2022] Stefan Kolek, Duc Anh Nguyen, Ron Levie, Joan Bruna, and Gitta Kutyniok. A rate-distortion framework for explaining black-box model decisions. In International Workshop on Extending Explainable AI Beyond Deep Models and Classifiers, pages 91–115. Springer, 2022.
- Kwon and Zou [2022] Yongchan Kwon and James Zou. Weightedshap: analyzing and improving shapley based feature attributions. arXiv preprint arXiv:2209.13429, 2022.
- LeCun et al. [2015] Yann LeCun, Yoshua Bengio, and Geoffrey Hinton. Deep learning. nature, 521(7553):436–444, 2015.
- Lei et al. [2018] Jing Lei, Max G’Sell, Alessandro Rinaldo, Ryan J Tibshirani, and Larry Wasserman. Distribution-free predictive inference for regression. Journal of the American Statistical Association, 113(523):1094–1111, 2018.
- Liu et al. [2022] Molei Liu, Eugene Katsevich, Lucas Janson, and Aaditya Ramdas. Fast and powerful conditional randomization testing via distillation. Biometrika, 109(2):277–293, 2022.
- Liu et al. [2021] Ruishan Liu, Shemra Rizzo, Samuel Whipple, Navdeep Pal, Arturo Lopez Pineda, Michael Lu, Brandon Arnieri, Ying Lu, William Capra, Ryan Copping, et al. Evaluating eligibility criteria of oncology trials using real-world data and ai. Nature, 592(7855):629–633, 2021.
- Liu and Xie [2020] Yaowu Liu and Jun Xie. Cauchy combination test: a powerful test with analytic p-value calculation under arbitrary dependency structures. Journal of the American Statistical Association, 115(529):393–402, 2020.
- Ljosa et al. [2012] Vebjorn Ljosa, Katherine L Sokolnicki, and Anne E Carpenter. Annotated high-throughput microscopy image sets for validation. Nature methods, 9(7):637–637, 2012.
- Lundberg and Lee [2017] Scott M Lundberg and Su-In Lee. A unified approach to interpreting model predictions. Advances in neural information processing systems, 30, 2017.
- Lundberg et al. [2020] Scott M Lundberg, Gabriel Erion, Hugh Chen, Alex DeGrave, Jordan M Prutkin, Bala Nair, Ronit Katz, Jonathan Himmelfarb, Nisha Bansal, and Su-In Lee. From local explanations to global understanding with explainable ai for trees. Nature machine intelligence, 2(1):56–67, 2020.
- Ma and Tourani [2020] Sisi Ma and Roshan Tourani. Predictive and causal implications of using shapley value for model interpretation. In Proceedings of the 2020 KDD Workshop on Causal Discovery, pages 23–38. PMLR, 2020.
- Merrick and Taly [2020] Luke Merrick and Ankur Taly. The explanation game: Explaining machine learning models using shapley values. In Machine Learning and Knowledge Extraction: 4th IFIP TC 5, TC 12, WG 8.4, WG 8.9, WG 12.9 International Cross-Domain Conference, CD-MAKE 2020, Dublin, Ireland, August 25–28, 2020, Proceedings 4, pages 17–38. Springer, 2020.
- Moncada-Torres et al. [2021] Arturo Moncada-Torres, Marissa C van Maaren, Mathijs P Hendriks, Sabine Siesling, and Gijs Geleijnse. Explainable machine learning can outperform cox regression predictions and provide insights in breast cancer survival. Scientific Reports, 11(1):1–13, 2021.
- Mosca et al. [2022] Edoardo Mosca, Ferenc Szigeti, Stella Tragianni, Daniel Gallagher, and George Louis Groh. Shap-based explanation methods: A review for nlp interpretability. In COLING, 2022.
- Nair and Hinton [2010] Vinod Nair and Geoffrey E Hinton. Rectified linear units improve restricted boltzmann machines. In Icml, 2010.
- Nguyen et al. [2019] Tuan-Binh Nguyen, Jérôme-Alexis Chevalier, and Bertrand Thirion. Ecko: Ensemble of clustered knockoffs for robust multivariate inference on fmri data. In International Conference on Information Processing in Medical Imaging, pages 454–466. Springer, 2019.
- Owen and Prieur [2017] Art B Owen and Clémentine Prieur. On shapley value for measuring importance of dependent inputs. SIAM/ASA Journal on Uncertainty Quantification, 5(1):986–1002, 2017.
- Owen [2013] Guillermo Owen. Game theory. Emerald Group Publishing, 2013.
- Paley and Zygmund [1932] Raymond EAC Paley and Antoni Zygmund. On some series of functions,(3). In Mathematical Proceedings of the Cambridge Philosophical Society, volume 28, pages 190–205. Cambridge University Press, 1932.
- Pearson [1933] Karl Pearson. On a method of determining whether a sample of size n supposed to have been drawn from a parent population having a known probability integral has probably been drawn at random. Biometrika, pages 379–410, 1933.
- Peleg and Sudhölter [2007] Bezalel Peleg and Peter Sudhölter. Introduction to the theory of cooperative games, volume 34. Springer Science & Business Media, 2007.
- Ribeiro et al. [2016] Marco Tulio Ribeiro, Sameer Singh, and Carlos Guestrin. "why should i trust you?" explaining the predictions of any classifier. In Proceedings of the 22nd ACM SIGKDD international conference on knowledge discovery and data mining, pages 1135–1144, 2016.
- Rozemberczki et al. [2022] Benedek Rozemberczki, Lauren Watson, Péter Bayer, Hao-Tsung Yang, Olivér Kiss, Sebastian Nilsson, and Rik Sarkar. The shapley value in machine learning. arXiv preprint arXiv:2202.05594, 2022.
- Rudin [2019] Cynthia Rudin. Stop explaining black box machine learning models for high stakes decisions and use interpretable models instead. Nature Machine Intelligence, 1(5):206–215, 2019.
- Selvaraju et al. [2017] Ramprasaath R Selvaraju, Michael Cogswell, Abhishek Das, Ramakrishna Vedantam, Devi Parikh, and Dhruv Batra. Grad-cam: Visual explanations from deep networks via gradient-based localization. In Proceedings of the IEEE international conference on computer vision, pages 618–626, 2017.
- Sesia and Sun [2022] Matteo Sesia and Tianshu Sun. Individualized conditional independence testing under model-x with heterogeneous samples and interactions. arXiv preprint arXiv:2205.08653, 2022.
- Sesia et al. [2021] Matteo Sesia, Stephen Bates, Emmanuel Candès, Jonathan Marchini, and Chiara Sabatti. False discovery rate control in genome-wide association studies with population structure. Proceedings of the National Academy of Sciences, 118(40):e2105841118, 2021.
- Shaffer [1995] Juliet Popper Shaffer. Multiple hypothesis testing. Annual review of psychology, 46(1):561–584, 1995.
- Shah et al. [2021] Harshay Shah, Prateek Jain, and Praneeth Netrapalli. Do input gradients highlight discriminative features? Advances in Neural Information Processing Systems, 34, 2021.
- Shapley [1951] Lloyd S Shapley. Notes on the N-person Game. Rand Corporation, 1951.
- Shin [2021] Donghee Shin. The effects of explainability and causability on perception, trust, and acceptance: Implications for explainable ai. International Journal of Human-Computer Studies, 146:102551, 2021.
- Shrikumar et al. [2017] Avanti Shrikumar, Peyton Greenside, and Anshul Kundaje. Learning important features through propagating activation differences. In International conference on machine learning, pages 3145–3153. PMLR, 2017.
- Sundararajan and Najmi [2020] Mukund Sundararajan and Amir Najmi. The many shapley values for model explanation. In International conference on machine learning, pages 9269–9278. PMLR, 2020.
- Tansey et al. [2022] Wesley Tansey, Victor Veitch, Haoran Zhang, Raul Rabadan, and David M Blei. The holdout randomization test for feature selection in black box models. Journal of Computational and Graphical Statistics, 31(1):151–162, 2022.
- Teneggi et al. [2022a] Jacopo Teneggi, Alexandre Luster, and Jeremias Sulam. Fast hierarchical games for image explanations. IEEE Transactions on Pattern Analysis and Machine Intelligence, pages 1–11, 2022a. doi: 10.1109/TPAMI.2022.3189849.
- Teneggi et al. [2022b] Jacopo Teneggi, Paul H Yi, and Jeremias Sulam. Weakly supervised learning significantly reduces the number of labels required for intracranial hemorrhage detection on head ct. arXiv preprint arXiv:2211.15924, 2022b.
- Tippett et al. [1931] Leonard Henry Caleb Tippett et al. The methods of statistics. The Methods of Statistics., 1931.
- Tomsett et al. [2018] Richard Tomsett, Dave Braines, Dan Harborne, Alun Preece, and Supriyo Chakraborty. Interpretable to whom? a role-based model for analyzing interpretable machine learning systems. arXiv preprint arXiv:1806.07552, 2018.
- Vaswani et al. [2017] Ashish Vaswani, Noam Shazeer, Niki Parmar, Jakob Uszkoreit, Llion Jones, Aidan N Gomez, Łukasz Kaiser, and Illia Polosukhin. Attention is all you need. Advances in neural information processing systems, 30, 2017.
- Verdinelli and Wasserman [2021] Isabella Verdinelli and Larry Wasserman. Decorrelated variable importance. arXiv preprint arXiv:2111.10853, 2021.
- Verdinelli and Wasserman [2023] Isabella Verdinelli and Larry Wasserman. Feature importance: A closer look at shapley values and loco. arXiv preprint arXiv:2303.05981, 2023.
- Vovk and Wang [2020] Vladimir Vovk and Ruodu Wang. Combining p-values via averaging. Biometrika, 107(4):791–808, 2020.
- Wang and Jia [2023] Jiachen T Wang and Ruoxi Jia. Data banzhaf: A robust data valuation framework for machine learning. In International Conference on Artificial Intelligence and Statistics, pages 6388–6421. PMLR, 2023.
- Watson et al. [2023] David S Watson, Joshua O’Hara, Niek Tax, Richard Mudd, and Ido Guy. Explaining predictive uncertainty with information theoretic shapley values. arXiv preprint arXiv:2306.05724, 2023.
- Wilson [2019] Daniel J Wilson. The harmonic mean p-value for combining dependent tests. Proceedings of the National Academy of Sciences, 116(4):1195–1200, 2019.
- Zaheer et al. [2017] Manzil Zaheer, Satwik Kottur, Siamak Ravanbakhsh, Barnabas Poczos, Russ R Salakhutdinov, and Alexander J Smola. Deep sets. Advances in neural information processing systems, 30, 2017.
- Zednik [2021] Carlos Zednik. Solving the black box problem: a normative framework for explainable artificial intelligence. Philosophy & Technology, 34(2):265–288, 2021.
- Zhou et al. [2016] Bolei Zhou, Aditya Khosla, Agata Lapedriza, Aude Oliva, and Antonio Torralba. Learning deep features for discriminative localization. In Proceedings of the IEEE conference on computer vision and pattern recognition, pages 2921–2929, 2016.
- Zoabi et al. [2021] Yazeed Zoabi, Shira Deri-Rozov, and Noam Shomron. Machine learning-based prediction of covid-19 diagnosis based on symptoms. npj digital medicine, 4(1):1–5, 2021.
Appendix A Proofs
We briefly summarize the notation used in this section. Recall that is a fixed predictor for a binary response on some input for an unknown distribution such that . For a sample and each subset denote the random vector that agrees with in the features in and that takes a reference value sampled from its conditional distribution in its complement . For brevity, we write . Finally, for a feature , and a subset denote
| (19) |
the random marginal contribution of feature to subset such that
| (20) |
are the expected -value of the SHAP-XRT procedure and the expected marginal contribution, respectively.
A.1 Proof of Theorem 1
Here, we show that the -value returned by the SHAP-XRT procedure is valid, i.e. under .
Proof.
Recall that given a sample , a feature , and a subset , the null hypothesis of the test is
| (21) |
Denote the random matrices containing duplicates of and , respectively, such that and are the predictions of the model. By definition, under
| (22) |
, are i.i.d. hence exchangeable. It follows that for any choice of test statistic , the random variables are also exchangeable. We conclude that . ∎
A.2 Proof of Theorem 2
Here, we prove the bounds on the expected -value of the SHAP-XRT procedure presented in Theorem 2.
A.2.1 Useful inequalities
We start by including some known inequalities that will become useful in the proof of our theorem.
Proposition A.1 (Paley-Zygmund’s inequality [61]).
If is a nonnegative random variable with finite variance, and , then
| (23) |
Proposition A.2 (Bhatia-Davis’ inequality [4]).
If is a bounded random variable in , then
| (24) |
A.2.2 Lemmas
We present two lemmas that provide upper and lower bounds to the negative tail of , respectively. Note that because . Herein, we define the nonnegative random variable such that
| (25) |
Lemma A.1 (Upper bound).
By Markov’s inequality, it holds that
| (26) |
Proof.
Applying Markov’s inequality to directly yields
| (27) |
∎
Lemma A.2 (Lower bound).
If , by the Paley-Zygmund’s and Bhatia-Davis’ inequalities, it holds that
| (28) |
Proof.
Note that and let . Then, the Paley-Zygmund’s inequality yields
| (29) |
Since , the Bhatia-Davis’ inequality implies
| (30) | ||||
| (31) | ||||
| (32) |
Therefore,
| (33) | ||||
| (34) |
∎
A.2.3 Proof of Eq. 11
Here, we show that
| (35) |
where is the number of draws of null statistic in the SHAP-XRT procedure.
A.2.4 Proof of Eq. 12
Here, we show that if
| (42) |
where is the number of draws of null statistic in the SHAP-XRT procedure.
A.3 Proof of Lemma 1
Here, we prove that
| (45) |
is a valid -value for .
A.4 Proof of Corollary 1
Here, we prove that the Shapley value of feature can be used to test for a global null hypothesis
| (46) |
A.5 Proof of Corollary 2
Here, we prove the bounds on the expected -value of the global SHAP-XRT null hypothesis presented in Corollary 2.
A.5.1 Proof of Eq. 17
Here, we show that if , then
| (53) |
where .
Proof.
Suppose and fix such that
| (54) |
which implies
| (55) | |||||
| () | (56) | ||||
| () | (57) | ||||
| (58) | |||||
Note that the last inequality follows from being an increasing function of for . Then,
| (59) |
∎
A.5.2 Proof of Eq. 18
Here, we show that if with , then
| (60) |
Proof.
Similarly to above, suppose and fix such that
| (61) |
which implies
| (62) |
and . Then,
| (63) |
∎
Appendix B Axioms of the Shapley value
Recall that the tuple is an -person TU game with characteristic function , such that is the score accumulated by the players in the coalition . Then, the Shapley values of the game (see Definition 1) are the only solution concept that satisfies the following axioms [72]:
Axiom 1 (Additivity).
The Shapley values sum up to the utility accumulated when all players participate in the game (i.e. the grand coalition of the game)
| (64) |
Axiom 2 (Nullity).
If a player does not contribute to any coalition, its Shapley value is 0
| (65) |
Axiom 3 (Symmetry).
If the contributions of two players to any coalition are the same, their Shapley values are the same
| (66) |
Axiom 4 (Linearity).
Given , the Shapley value of the union of the two games (i.e. ) is equal to the sum of the Shapley values of the individual games (i.e. and , respectively)
| (67) |
Finally, we note that Axioms 2–4 can be replaced by a fifth one, usually referred to as balanced contribution [26], although this is not necessary to derive the definition of the Shapley value.
Appendix C Algorithms
Appendix D Experimental details
Before describing the experimental details, we note that all experiments were run on an NVIDIA Quadro RTX 5000 with of RAM memory on a private server with 96 CPU cores. All scripts were run on PyTorch 1.11.0, Python 3.8.13, and CUDA 10.2.
D.1 Synthetic image data
Here, we describe the model architectures and the training details for the synthetic image datasets. Recall that are images composed of an grid of non-overlapping patches of pixels, such that is the patch in the -row and -column.
We train a CNN with one filter with stride , and a two-layer FCN with ReLU activation. In particular:
| (68) | ||||
| and | ||||
| (69) | ||||
where is the sigmoid function, and is the rectified linear unit [57]. We train both models for one epoch on i.i.d. samples and a batch size of 64. We note that we use Adam [41] with learning rate of , and SGD with learning rate of for and , respectively, to achieve optimal validation accuracy.
D.2 Real image data
Here, we present the details of the training process for the experiment on the BBBC041 dataset [50] (which is publicly available at https://bbbc.broadinstitute.org/BBBC041). Recall that the dataset comprises 1425 images of healthy and infected human blood smears. We split the original dataset into a training and validation split using an 80/20 ratio, respectively. This way, we train our model on 589 positive and 608 negative images, and validate on 112 positive and 116 negative images.
We apply transfer learning to a ResNet18 [31] pretrained on ImageNet [20]. We optimize all parameters of the network for 25 epochs using binary-cross entropy loss and Adam optimizer, with a learning rate of 0.0001 and learning rate decay of 0.2 every 10 epochs. At training time, we augment the dataset with random horizontal flips.
Appendix E Supplementary results for real image data experiment



Here, we revisit the real image data experiment presented in Section 4. Instead of using 4 quadrants, we further subdivide them to obtain 16 features, , as displayed in Fig. 1(a). The input image contains 6 trophozoites that are highlighted with green bounding boxes. For each feature, we compute the -values of all SHAP-XRT null hypotheses. Figs. 1(c) and 1(b) show the SHAP-XRT heatmaps for features (which contains a trophozoite) and (which does not contain a trophozoite), respectively. In the heatmaps, each feature is colored accordingly to the number of SHAP-XRT null hypotheses that are rejected. That is, the higher number of tests are rejected such that , the stronger the color of feature . Fig. 1(b) shows that for an important feature (i.e., a feature that does contain a trophozoite), the heatmap concentrates on features that do not contain any trophozoites. This agrees with intuition that when does not contain any trophozoites, adding a feature with a trophozoite will affect the distribution of the output of the model. Symmetrically, when already contains some trophozoites, adding another will not affect the distribution. Fig. 1(c) shoes that for an unimportant feature (i.e., a feature that does not contain a trophozoite), the heatmap is empty because no matter whether contains a trophozoite, adding an empty feature will not affect the distribution of the response.
Appendix F Figures
Here we include supplementary figures.